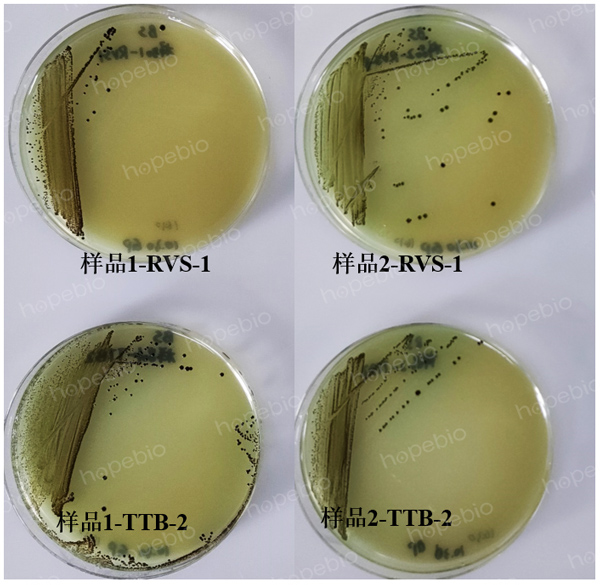
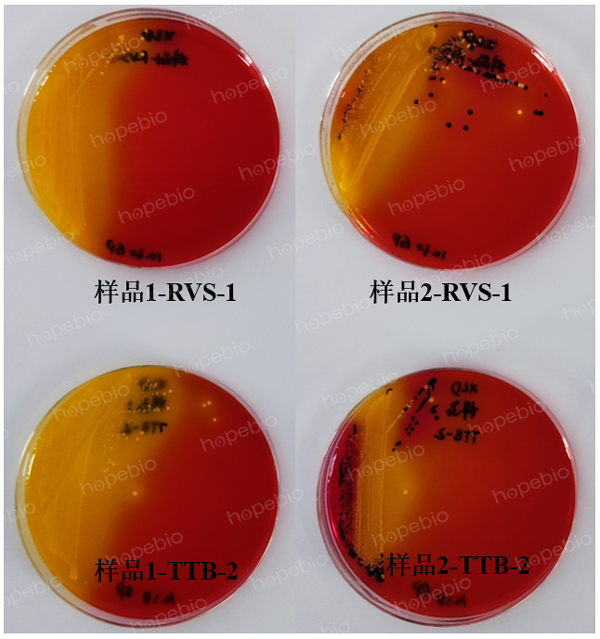
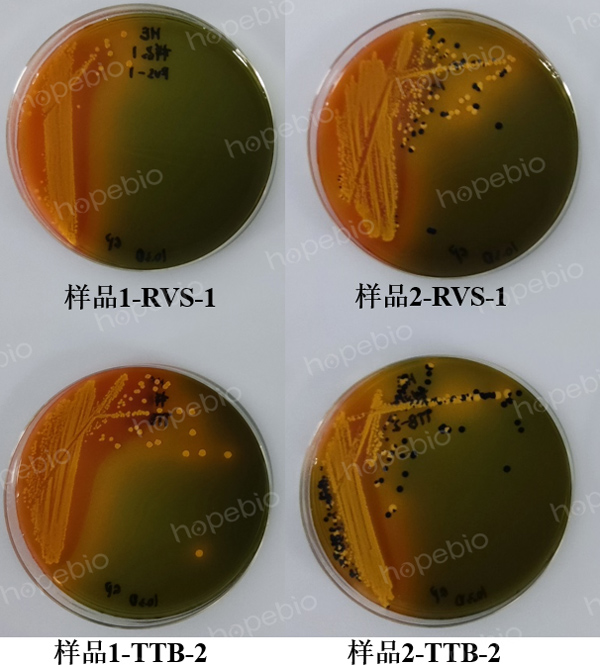
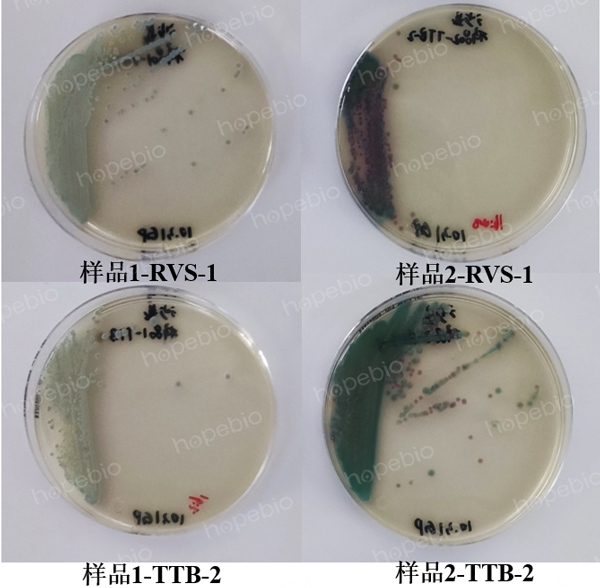

海博微信公众号
海博微信公众号
 海博天猫旗舰店
海博天猫旗舰店


 海博微信公众号
海博微信公众号
 海博天猫旗舰店
海博天猫旗舰店




一、培养基简介
沙门氏菌显色培养基(第二代)是经过青岛海博公司改良的培养基,能直接鉴定所有沙门氏菌,特异性可达98%,准确度非常高,对沙门氏菌的生长有较好的选择性和灵敏度。作为我司主推产品之一,常用于食品中和其他样品中沙门氏菌的快速检测,可通过观察培养基上的菌落颜色来快速鉴定和分离沙门氏菌。其中沙门氏菌在培养基中显紫色,大肠菌群显蓝色,而其他菌群显黄色或者无色。
下面以两批次沙门氏菌盲样,按照“GB 4789.4-2024 食品微生物检验-沙门氏菌检验”的流程,阐述我司沙门显色培养基在检测方面的高效性和准确性。
二、试验材料
两批次沙门氏菌盲样,分别记为样品1和样品2,按照GB 4789.4-2024的要求,经过225 mL BPW进行预增菌培养,得到培养物。
三、试验方法
按照GB 4789.4-2024的检验程序,进行各步骤操作。
四、试验结果
1.选择性增菌
为了对目标菌群进行选择性培养,需要将BPW培养物分别接种到RVS和TTB培养基中,进行选择性增菌,具体操作如下:
摇动预增菌培养物样品1,取0.1mL转种于10mL RVS,1mL转种于10mL TTB中,混匀后置于42℃±1℃培养18h-24h。样品2培养物处理步骤同样品1。

图1 样品1和样品2培养物在RVS肉汤管的选择性增菌结果

图2 样品1和样品2培养物在TTB增菌液的选择性增菌结果
由图1可知,“样品1 RVS-1”、“样品2 RVS-1”和“样品2 RVS-2”相较于对照组,试管内均出现不同程度的浑浊;由图2可知,“样品1 TTB-1”、“样品1 TTB-2”、“样品2 TTB-1”和“样品2 TTB-2”试管均出现不同浑浊现象,表明样品1和样品2均有可能含有目标菌群,因此需要继续目标菌群的分离工作。
2.分离
为了筛选出可疑的目标菌株,对选择性增菌液培养物进行菌株分离,具体操作如下:
振荡混匀选择性增菌的培养物后,用直径3mm的接种环取每种选择性增菌的培养物各一环,分别划线接种于一个BS琼脂平板和一个XLD琼脂平板(也可使用HE琼脂平板、沙门氏菌显色培养基平板或其他合适的分离琼脂平板),于36°C±1°C分别培养40h~48h(BS琼脂平板)或18h~24h(XLD琼脂平板、HE琼脂平板、沙门氏菌显色培养基平板),观察各个平板上生长的菌落,是否符合表1的菌落特征。
表1 不同分离琼脂平板上沙门氏菌的菌落特征
|
分离琼脂平板 |
菌落特征 |
|
BS琼脂 |
菌落为黑色有金属光泽、棕褐色或灰色,菌落周围培养基可呈黑色或棕色;有些菌株形成灰绿色的菌落,周围培养基不变色; |
|
XLD琼脂 |
菌落呈粉红色,带或不带黑色中心,有些菌株可呈现大的带光泽的黑色中心,或呈现全部黑色的菌落;有些菌株为黄色菌落,带或不带黑色中心; |
|
HE琼脂 |
蓝绿色或蓝色,多数菌落中心黑色或几乎全黑色;有些菌株为黄色,中心黑色或几乎全黑色; |
|
沙门氏菌显色培养基 |
菌落为紫色; |
图3 样品1和样品2培养物在BS琼脂的菌落特征
图4 样品1和样品2培养物在XLD琼脂的菌落特征
图5 样品1和样品2培养物在HE琼脂的菌落特征
图6 样品1和样品2培养物在沙门氏菌显色培养基的菌落特征
根据表1中沙门氏菌在不同分离琼脂的菌落特性,分别对样品1和样品2培养物在BS琼脂、XLD琼脂、HE琼脂和沙门氏菌显色培养基的菌落特征进行逐一分析。如图3所示,样品1和样品2培养物在BS琼脂均表现出“菌落为金属光泽黑色、灰绿色菌落”等疑似沙门氏菌特征;如图4所示,样品1和样品2培养物在XLD琼脂均表现出“黑色菌落、黄色菌落且带或不带黑色中心”等疑似沙门氏菌特征;如图5所示,样品1培养物在HE琼脂平板中只有黄色菌落,并无其他沙门氏菌菌落特征,而样品2培养物表现出中心为全黑色的菌落特征;如图5所示,根据沙门氏菌显色培养基的紫色菌落特征,只有含有样品2培养物的平板会出现紫色菌落,而样品1培养物的平板并没有沙门氏菌的菌落颜色特征,此时可以初步得出一个结论,样品2很可能含有沙门氏菌,而样品1不含有沙门氏菌的概率比较大。
3.生化试验
挑取4个以上典型或可疑菌落进行生化试验,这些菌落宜分别来自不同选择性增菌液的不同分离琼脂。将典型或可疑菌落接种三糖铁琼脂,先在斜面划线,再于底层穿刺;同时接种赖氨酸脱羧酶试验培养基和营养琼脂(或其他合适的非选择性固体培养基)平板,于36℃ ±1℃培养18h~24h。三糖铁和赖氨酸脱羧酶试验的结果及初步判断见表2。将已挑菌落的分离琼脂平板于2℃~8℃保存,以备必要时复查。
初步判断为非沙门氏菌者,直接报告结果。对疑似沙门氏菌者,从营养琼脂平板上挑取其纯培养物接种蛋白胨水(供做靛基质试验)、尿素琼脂(pH7.2)、氰化钾(KCN)培养基,也可在接种三糖铁琼脂和赖氨酸脱羧酶试验培养基的同时,接种以上3种生化试验培养基,于36℃±1℃培养18h~24h,按表3判定结果。
表2 三糖铁和赖氨酸脱羧酶试验结果及初步判断

表3 生化试验结果鉴别表


图7 样品1培养物的三糖铁试验结果

图8 样品2培养物的三糖铁试验结果



图9 样品2培养物在沙门氏菌生化鉴定条的试验结果



图10 样品1和样品2培养物在沙门氏菌生化鉴定条(GB)试验结果
根据表2、表3、三糖铁试验和生化管试验的结果表明,样品1在三糖铁琼脂中斜面和底层都只产酸,且没有硫化氢的产生;靛基质为阳性,不符合沙门氏菌的典型生化反应,所以样品1不含有沙门氏菌,这与样品1在沙门显色培养中均无明显紫色菌落特征的结果相对应。
样品2(含有黑色中心菌落)在三糖铁琼脂中斜面产碱变红,底层产酸变红,且都有产气产硫化氢的现象;生化试验表现为靛基质、尿素(pH7.2)和氰化钾为阴性,赖氨酸脱羧酶为阳性,为典型的沙门氏菌生化反应,后续进行血清学鉴定后报告结果,所以样品2含有沙门氏菌,与样品2在沙门显色培养基中呈现出紫色菌落特征的结果相呼应。
五、总结
沙门氏菌在BS琼脂、XLD琼脂和HE琼脂中均不具有唯一的菌落特征,每一种培养基均有两种以上的菌落颜色,且每个特征菌落的三糖铁和生化鉴定条试验结果不一定为沙门氏菌的典型反应,因此加大了检测过程中的难度和判断力,难以快速得出结论。而沙门氏菌在沙门显色培养的唯一紫色菌落特征,有利于检测人员提前对待测样品做出预判,缩短检测时间,提高工作效率。
六、沙门氏菌检验操作视频及相关培养基的采购
1.沙门氏菌检验试验操作视频,具体可以参照海博生物官网,里面有详细的步骤解说。视频演示-实验操作视频-使用说明演示视频(hopebiol.com)
2.青岛高科技工业园区海博生物技术有限公司有各种涉及沙门氏菌检验相关的培养基,欢迎广大新老客户采购使用。
表4 海博生物沙门氏菌相关培养基的种类及货号
|
海博生物-货号 |
培养基名称 |
规格 |
|
HBPT4086 |
四硫磺酸盐煌绿增菌液(TTB肉汤)管(10mL) |
10mL*20支/盒 |
|
HBPT4198 |
RVS肉汤管(10mL) |
10mL*20支 |
|
HB4090-6 |
亚硫酸铋(BS)琼脂 |
250g |
|
HB4105-12 |
木糖赖氨酸脱氧胆盐(XLD)琼脂(GB4789.4-2024标准) |
250g |
|
HB4093 |
HE琼脂 |
250g |
|
HB7007-1 |
沙门氏菌显色培养基(第二代) |
1000mL |
|
HBIG01 |
HBI沙门氏菌生化鉴定条(GB) |
5条/盒 |
|
HB4088-13 |
三糖铁(TSI)琼脂(GB4789.4-2024标准) |
250g |
注:本文属海博生物原创,未经允许不得转载。
上一篇:琼脂含量对动力试验结果的影响
下一篇:没有了!



